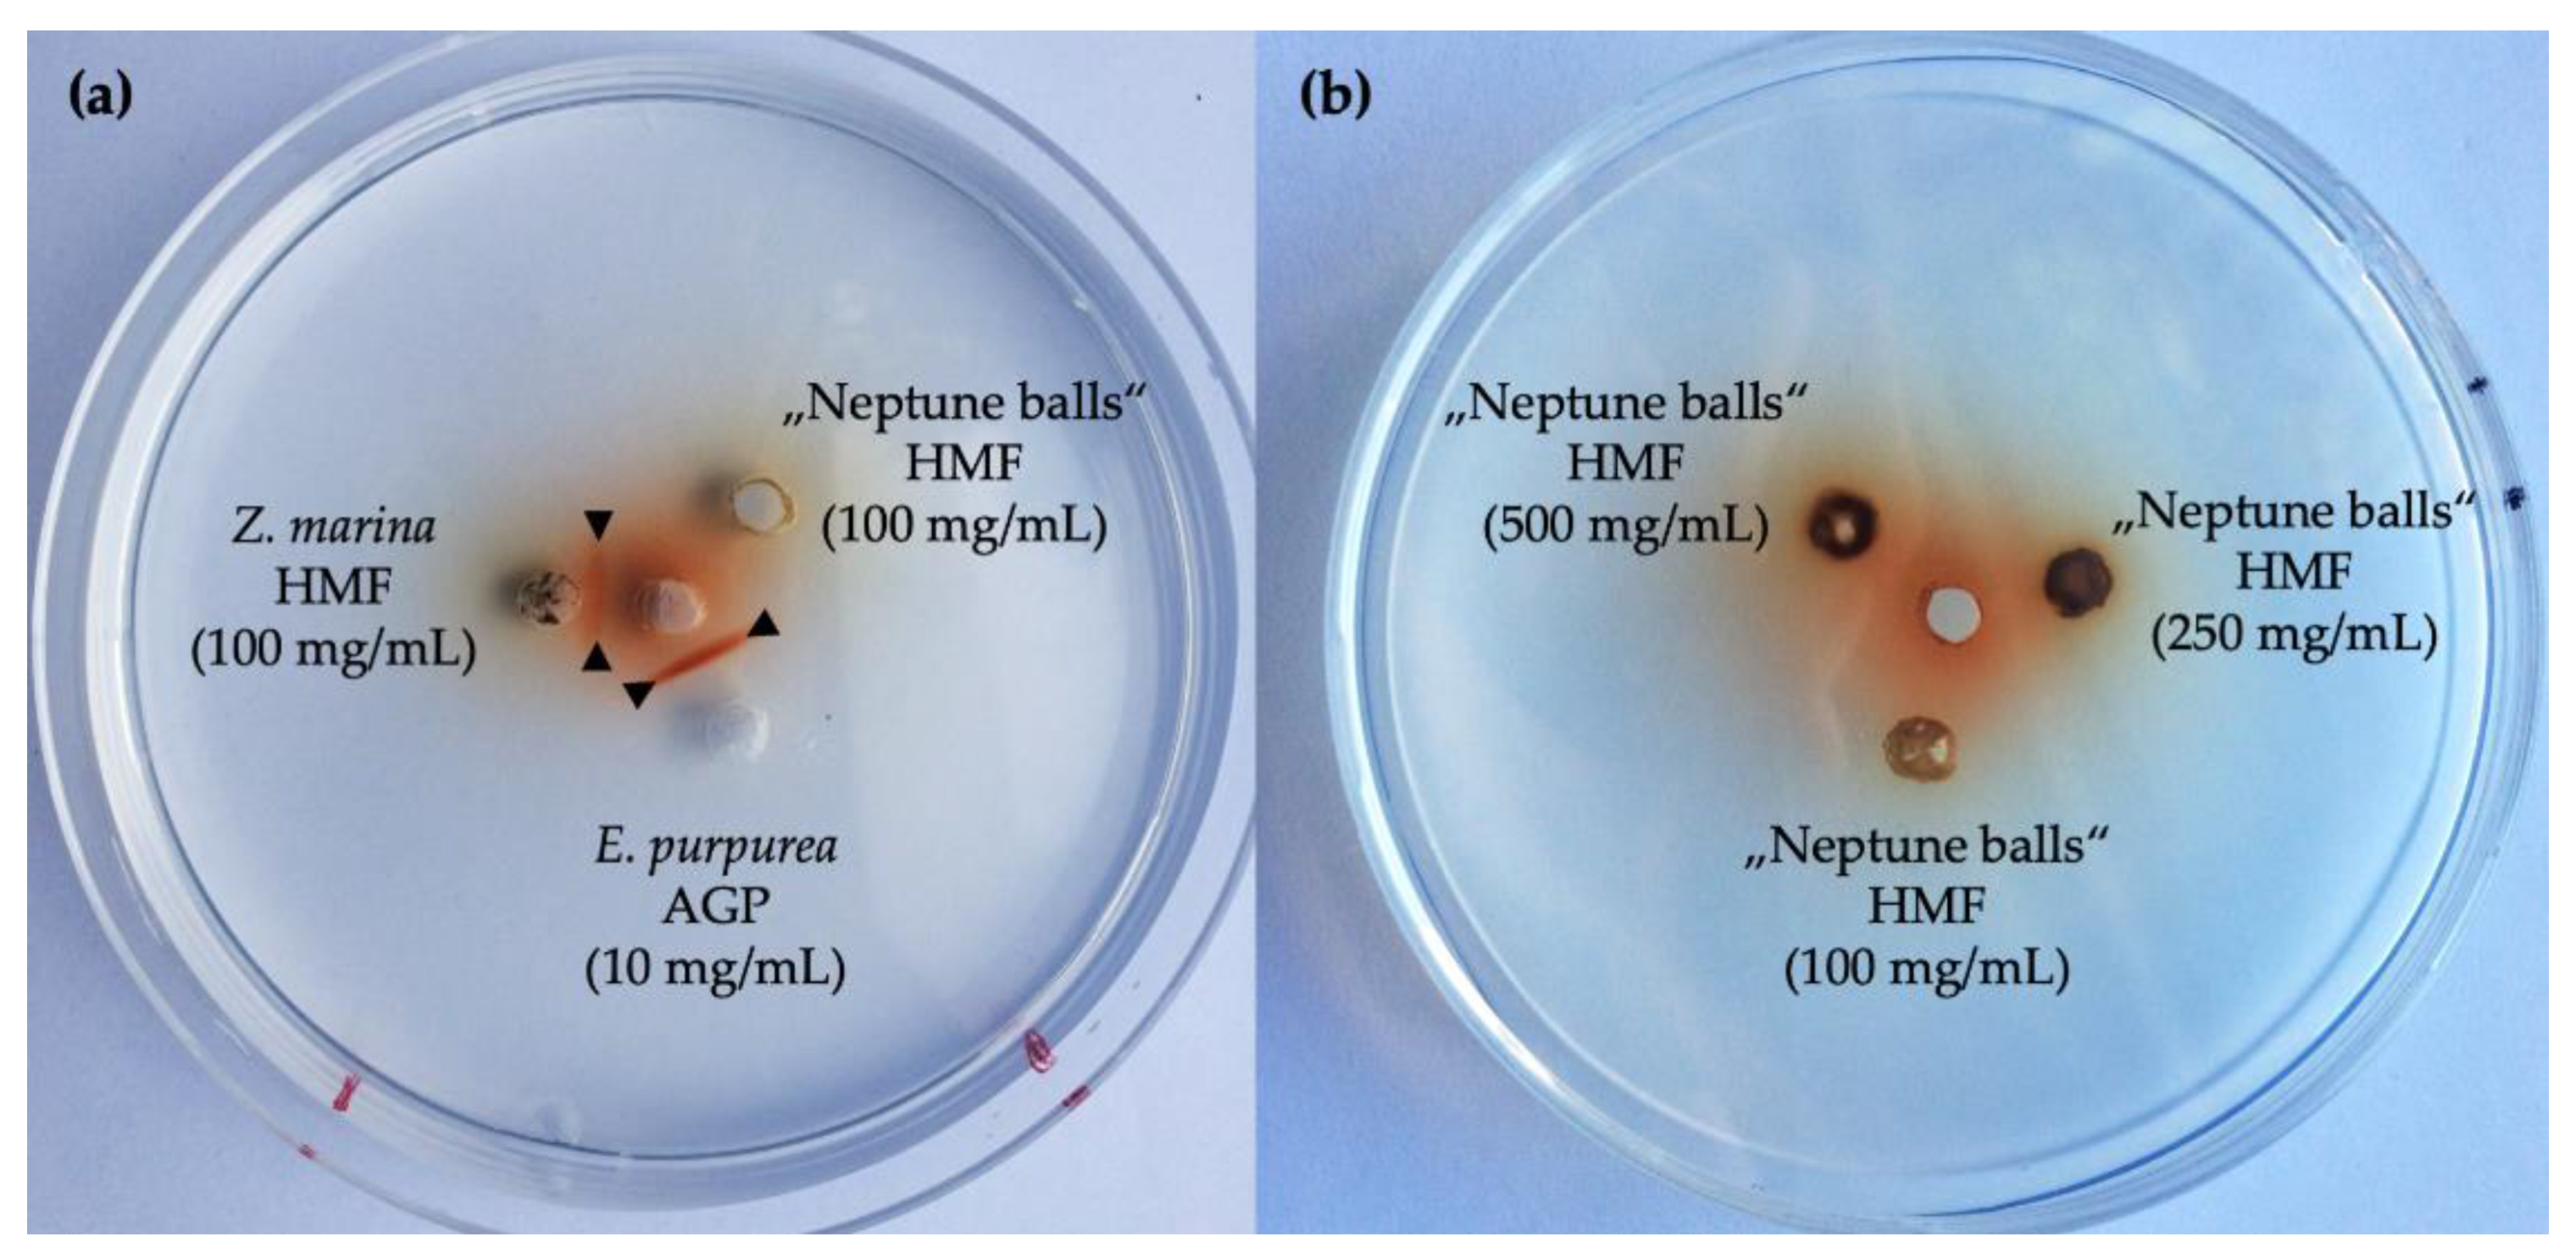

“Neptune Balls” Polysaccharides: Disentangling the Wiry Seagrass Detritus
Abstract
:1. Introduction
2. Materials and Methods
2.1. Plant Material
2.2. Extraction Procedure
2.3. Geldiffusion Assay with Yariv-Reagent
2.4. Purification with Yariv-Reagent
2.5. Purification by Ion-Exchange Chromatography (IEC)
2.6. Neutral Monosaccharide Composition
2.7. Uronic Acid Determination
2.8. Linkage-Type Analysis
2.9. Elemental Analysis
2.10. FT-IR Spectrometry
3. Results
3.1. Fractionated Cell Wall Extraction
3.2. FT-IR Spectrometry
3.3. Presence of Arabinogalactan Structures
3.4. Purification of Xylans from the HCl Fraction by Ion-Exchange Chromatography
3.5. Linkage-Type Analysis of Xylan Structures
4. Discussion
4.1. Xylans
4.2. Possible Usage Options
5. Conclusions
Funding
Institutional Review Board Statement
Informed Consent Statement
Data Availability Statement
Acknowledgments
Conflicts of Interest
Appendix A
| Mono- Saccharides | AE | AmOx | HCl | Carb. | KOH |
|---|---|---|---|---|---|
| Rhamnose | 4.5 (±0.7) | 5.5 (±0.6) | 1.1 (±0.2) | 2.0 (±0.2) | 0.2 (±0.2) |
| Fucose | 2.5 (±0.4) | 2.8 (±0.2) | 0.5 (±0.1) | - | - |
| Arabinose | 11.7 (±1.7) | 12.6 (±2.7) | 2.9 (±0.9) | 7.8 (±4.4) | 4.1 (±4.0) |
| Xylose | 61.4 (±2.2) | 56.9 (±1.6) | 90.2 (±1.6) | 81.8 (±4.6) | 88.4 (±6.3) |
| Apiose | - | 2.8 (±0.2) | 1.8 (±0.3) | - | 0.6 (±0.5) |
| Mannose | 3.7 (± 0.7) | 3.8 (±1.0) | 0.2 (±0.3) | 1.4 (±0.3) | 2.7 (±0.7) |
| Galactose | 9.5 (±1.5) | 10.5 (±0.2) | 2.3 (±0.3) | 5.3 (±0.5) | 2.0 (±0.8) |
| Glucose | 6.7 (±0.7) | 5.1 (±0.6) | 1.0 (±0.2) | 1.7 (±0.1) | 2.0 (±1.5) |
| Uronic acids | 4.9 | 9.5 | 8.5 | 4.3 | 0.9 |
References
- Van Den Hoek, C. Revision of the European Species of Cladophora; Brill Archive: Leiden, The Netherlands, 1963. [Google Scholar]
- Den Hartog, C.; Kuo, J. Taxonomy and Biogeography of Seagrasses. In Seagrasses: Biology, Ecology and Conservation; Springer: Dordrecht, The Netherlands, 2006; pp. 1–23. ISBN 978-1-4020-2942-4. [Google Scholar]
- Aires, T.; Marbà, N.; Cunha, R.; Kendrick, G.; Walker, D.; Serrão, E.; Duarte, C.; Arnaud-Haond, S. Evolutionary History of the Seagrass Genus Posidonia. Mar. Ecol. Prog. Ser. 2011, 421, 117–130. [Google Scholar] [CrossRef] [Green Version]
- Duarte, C.M.; Chiscano, C.L. Seagrass Biomass and Production: A Reassessment. Aquat. Bot. 1999, 65, 159–174. [Google Scholar] [CrossRef]
- Boudouresque, C.F.; Pergent, G.; Pergent-Martini, C.; Ruitton, S.; Thibaut, T.; Verlaque, M. The Necromass of the Posidonia oceanica Seagrass Meadow: Fate, Role, Ecosystem Services and Vulnerability. Hydrobiologia 2016, 781, 25–42. [Google Scholar] [CrossRef] [Green Version]
- Ceccherelli, G.; Campo, D.; Milazzo, M. Short-Term Response of the Slow Growing Seagrass Posidonia oceanica to Simulated Anchor Impact. Mar. Environ. Res. 2007, 63, 341–349. [Google Scholar] [CrossRef] [PubMed]
- Duarte, C.M. The Future of Seagrass Meadows. Environ. Conserv. 2002, 29, 192–206. [Google Scholar] [CrossRef] [Green Version]
- Boudouresque, C.-F.; Ponel, P.; Astruch, P.; Barceló, A.; Blanfuné, A.; Geoffroy, D.; Thibaut, T. The High Heritage Value of the Mediterranean Sandy Beaches, with a Particular Focus on the Posidonia oceanica “Banquettes”: A Review. Sci. Rep. Port-Cros Natl. Park 2017, 31, 23–70. [Google Scholar]
- Ardizzone, G.; Belluscio, A.; Maiorano, L. Long-Term Change in the Structure of a Posidonia oceanica Landscape and Its Reference for a Monitoring Plan. Mar. Ecol. 2006, 27, 299–309. [Google Scholar] [CrossRef]
- Montefalcone, M.; Chiantore, M.; Lanzone, A.; Morri, C.; Albertelli, G.; Bianchi, C.N. Baci Design Reveals the Decline of the Seagrass Posidonia oceanica Induced by Anchoring. Mar. Pollut. Bull. 2008, 56, 1637–1645. [Google Scholar] [CrossRef]
- Duarte, C.M. How Can Beaches Be Managed with Respect to Seagrass Litter. In European Seagrasses: An Introduction to Monitoring and Management; The M&MS Project: Hilleroed, Denmark, 2004; p. 83. [Google Scholar]
- Cannon, J.F.M. An Experimental Investigation of Posidonia Balls. Aquat. Bot. 1979, 6, 407–410. [Google Scholar] [CrossRef]
- Carmona, C.; Horrach, G.; Oliver, C.; Instituto Balear De La Vivienda; Forteza, F.J.; Muñoz, J. Posidonia oceanica as Thermal Insulation: Determination of the Minimum Bulk Density, According to Project Specifications, for Its Use as a Building Solution on a Flat Roof. Rdlc 2018, 250–257. [Google Scholar] [CrossRef]
- Bozsaky, D. Nature-Based Thermal Insulation Materials from Renewable Resources—A State-of-the-Art Review. Slovak J. Civ. Eng. 2019, 27, 52–59. [Google Scholar] [CrossRef] [Green Version]
- Mininni, C.; Santamaria, P.; Abdelrahman, H.M.; Cocozza, C.; Miano, T.; Montesano, F.; Parente, A. Posidonia-Based Compost as a Peat Substitute for Lettuce Transplant Production. Horts 2012, 47, 1438–1444. [Google Scholar] [CrossRef]
- Garcia-Garcia, D.; Quiles-Carrillo, L.; Montanes, N.; Fombuena, V.; Balart, R. Manufacturing and Characterization of Composite Fibreboards with Posidonia oceanica Wastes with an Environmentally-Friendly Binder from Epoxy Resin. Materials 2017, 11, 35. [Google Scholar] [CrossRef] [Green Version]
- Pavlakis, I. Environmentally Friendly Panel from the Dead Seagrass Leaves of Posidonia oceanica. International Patent PCT/GR2017/000043, 15 February 2018. [Google Scholar]
- Marilés, B.-A.; Jaime, G.-P.; Eva, B.-B.; Ignacio, M.; Pablo, D.-G. Fibers of the Seagrass Posidonia oceanica as Substrate for Germination of Lentil Seeds. Sn Appl. Sci. 2019, 1, 1414. [Google Scholar] [CrossRef] [Green Version]
- Olacia, E.; Pisello, A.L.; Chiodo, V.; Maisano, S.; Frazzica, A.; Cabeza, L.F. Sustainable Adobe Bricks with Seagrass Fibres. Mechanical and Thermal Properties Characterization. Constr. Build. Mater. 2020, 239, 117669. [Google Scholar] [CrossRef]
- Ncibi, M.C.; Mahjoub, B.; Seffen, M. biosorption of Phenol onto Posidonia oceanica (L.) Seagrass in Batch System: Equilibrium and Kinetic Modelling. Can. J. Chem. Eng. 2006, 84, 495–500. [Google Scholar] [CrossRef]
- Ncibi, M.C.; Mahjoub, B.; Seffen, M. Kinetic and Equilibrium Studies of Methylene Blue Biosorption by Posidonia oceanica (L.) Fibres. J. Hazard. Mater. 2007, 139, 280–285. [Google Scholar] [CrossRef]
- Ncibi, M.C.; Mahjoub, B.; Seffen, M. Adsorptive Removal of Anionic and Non-Ionic Surfactants from Aqueous Phase Using Posidonia oceanica (L.) Marine Biomass. J. Chem. Technol. Biotechnol. 2008, 83, 77–83. [Google Scholar] [CrossRef]
- Cengiz, S.; Cavas, L. A Promising Evaluation Method for Dead Leaves of Posidonia oceanica (L.) in the Adsorption of Methyl Violet. Mar. Biotechnol. 2010, 12, 728–736. [Google Scholar] [CrossRef]
- Dridi-Dhaouadi, S.; M’henni, M.F. Dynamic Study of Lead Removal from Aqueous Solution Using Posidonia oceanica Fixed Bed Column. Int. J. Appl. Chem. 2011, 7, 213–225. [Google Scholar]
- Saad, M.E.K.; Khiari, R.; Elaloui, E.; Moussaoui, Y. Adsorption of Anthracene Using Activated Carbon and Posidonia oceanica. Arab. J. Chem. 2014, 7, 109–113. [Google Scholar] [CrossRef] [Green Version]
- Ben Jmaa, S.; Kallel, A. Assessment of Performance of Posidona oceanica (L.) as Biosorbent for Crude Oil-Spill Cleanup in Seawater. Biomed Res. Int. 2019, 2019, 1–9. [Google Scholar] [CrossRef] [Green Version]
- Elmorsi, R.R.; El-Wakeel, S.T.; Shehab El-Dein, W.A.; Lotfy, H.R.; Rashwan, W.E.; Nagah, M.; Shaaban, S.A.; Sayed Ahmed, S.A.; El-Sherif, I.Y.; Abou-El-Sherbini, K.S. Adsorption of Methylene Blue and Pb2+ by Using Acid-Activated Posidonia oceanica Waste. Sci. Rep. 2019, 9, 3356. [Google Scholar] [CrossRef]
- Heglmeier, A.; Zidorn, C. Secondary Metabolites of Posidonia oceanica (Posidoniaceae). Biochem. Syst. Ecol. 2010, 38, 964–970. [Google Scholar] [CrossRef]
- Luzi, F.; Fortunati, E.; Puglia, D.; Petrucci, R.; Kenny, J.M.; Torre, L. Modulation of Acid Hydrolysis Reaction Time for the Extraction of Cellulose Nanocrystals from Posidonia oceanica Leaves. J. Renew. Mater. 2016, 4, 190–198. [Google Scholar] [CrossRef]
- Mirpoor, S.F.; Giosafatto, C.V.L.; Di Pierro, P.; Di Girolamo, R.; Regalado-González, C.; Porta, R. Valorisation of Posidonia Oceanica Sea Balls (Egagropili) as a Potential Source of Reinforcement Agents in Protein-Based Biocomposites. Polymers 2020, 12, 2788. [Google Scholar] [CrossRef] [PubMed]
- Puglia, D.; Petrucci, R.; Fortunati, E.; Luzi, F.; Kenny, J.M.; Torre, L. Revalorisation of Posidonia Oceanica as Reinforcement in Polyethylene/Maleic Anhydride Grafted Polyethylene Composites. J. Renew. Mater. 2014, 2, 66–76. [Google Scholar] [CrossRef]
- Seggiani, M.; Cinelli, P.; Mallegni, N.; Balestri, E.; Puccini, M.; Vitolo, S.; Lardicci, C.; Lazzeri, A. New Bio-Composites Based on Polyhydroxyalkanoates and Posidonia oceanica Fibres for Applications in a Marine Environment. Materials 2017, 10, 326. [Google Scholar] [CrossRef] [PubMed] [Green Version]
- Seggiani, M.; Cinelli, P.; Balestri, E.; Mallegni, N.; Stefanelli, E.; Rossi, A.; Lardicci, C.; Lazzeri, A. Novel Sustainable Composites Based on Poly(Hydroxybutyrate-Co-Hydroxyvalerate) and Seagrass Beach-Cast Fibers: Performance and Degradability in Marine Environments. Materials 2018, 11, 772. [Google Scholar] [CrossRef] [Green Version]
- Benito-González, I.; López-Rubio, A.; Martínez-Sanz, M. Potential of Lignocellulosic Fractions from Posidonia oceanica to Improve Barrier and Mechanical Properties of Bio-Based Packaging Materials. Int. J. Biol. Macromol. 2018, 118, 542–551. [Google Scholar] [CrossRef]
- Benito-González, I.; López-Rubio, A.; Gavara, R.; Martínez-Sanz, M. Cellulose Nanocrystal-Based Films Produced by More Sustainable Extraction Protocols from Posidonia Oceanica Waste Biomass. Cellulose 2019, 26, 8007–8024. [Google Scholar] [CrossRef]
- Pettolino, F.A.; Walsh, C.; Fincher, G.B.; Bacic, A. Determining the Polysaccharide Composition of Plant Cell Walls. Nat. Protoc. 2012, 7, 1590–1607. [Google Scholar] [CrossRef] [PubMed]
- Pfeifer, L.; Shafee, T.; Johnson, K.L.; Bacic, A.; Classen, B. Arabinogalactan-Proteins of Zostera Marina L. Contain Unique Glycan Structures and Provide Insight into Adaption Processes to Saline Environments. Sci. Rep. 2020, 10, 8232. [Google Scholar] [CrossRef]
- Raimundo, S.C.; Avci, U.; Hopper, C.; Pattathil, S.; Hahn, M.G.; Popper, Z.A. Immunolocalization of Cell Wall Carbohydrate Epitopes in Seaweeds: Presence of Land Plant Epitopes in Fucus vesiculosus L. (Phaeophyceae). Planta 2016, 243, 337–354. [Google Scholar] [CrossRef]
- O’rourke, C.; Gregson, T.; Murray, L.; Sadler, I.H.; Fry, S.C. Sugar Composition of the Pectic Polysaccharides of Charophytes, the Closest Algal Relatives of Land-Plants: Presence of 3-O-Methyl-D-Galactose Residues. Ann. Bot. 2015, 116, 225–236. [Google Scholar] [CrossRef] [Green Version]
- Happ, K.; Classen, B. Arabinogalactan-Proteins from the Liverwort Marchantia polymorpha L., a Member of a Basal Land Plant Lineage, Are Structurally Different to Those of Angiosperms. Plants 2019, 8, 460. [Google Scholar] [CrossRef] [Green Version]
- Bartels, D.; Classen, B. Structural Investigations on Arabinogalactan-Proteins from a Lycophyte and Different Monilophytes (Ferns) in the Evolutionary Context. Carbohydr. Polym. 2017, 172, 342–351. [Google Scholar] [CrossRef]
- Bartels, D.; Baumann, A.; Maeder, M.; Geske, T.; Heise, E.M.; Von Schwartzenberg, K.; Classen, B. Evolution of Plant Cell Wall: Arabinogalactan-Proteins from Three Moss Genera Show Structural Differences Compared to Seed Plants. Carbohydr. Polym. 2017, 163, 227–235. [Google Scholar] [CrossRef]
- Baumann, A.; Pfeifer, L.; Classen, B. Arabinogalactan-Proteins from Non-Coniferous Gymnosperms Have Unusual Structural Features. Carbohydr. Polym. 2021, 261, 117831. [Google Scholar] [CrossRef]
- Yariv, J.; Rapport, M.; Graf, L. The Interaction of Glycosides and Saccharides with Antibody to the Corresponding Phenylazo Glycosides. Biochem. J. 1962, 85, 383–388. [Google Scholar] [CrossRef] [Green Version]
- Yariv, J.; Lis, H.; Katchalski, E. Precipitation of Arabic Acid and Some Seed Polysaccharides by Glycosylphenylazo Dyes. Biochem. J. 1967, 105, 1c–2c. [Google Scholar] [CrossRef] [PubMed] [Green Version]
- Dubois, M.; Gilles, K.A.; Hamilton, J.K.; Rebers, P.T.; Smith, F. Colorimetric Method for Determination of Sugars and Related Substances. Anal. Chem. 1956, 28, 350–356. [Google Scholar] [CrossRef]
- Blakeney, A.B.; Harris, P.J.; Henry, R.J.; Stone, B.A. A Simple and Rapid Preparation of Alditol Acetates for Monosaccharide Analysis. Carbohydr. Res. 1983, 113, 291–299. [Google Scholar] [CrossRef]
- Blumenkrantz, N.; Asboe-Hansen, G. New Method for Quantitative Determination of Uronic Acids. Anal. Biochem. 1973, 54, 484–489. [Google Scholar] [CrossRef]
- Harris, P.J.; Henry, R.J.; Blakeney, A.B.; Stone, B.A. An Improved Procedure for the Methylation Analysis of Oligosaccharides and Polysaccharides. Carbohydr. Res. 1984, 127, 59–73. [Google Scholar] [CrossRef]
- Buslov, D.K.; Kaputski, F.N.; Sushko, N.I.; Torgashev, V.I.; Solov’eva, L.V.; Tsarenkov, V.M.; Zubets, O.V.; Larchenko, L.V. Infrared Spectroscopic Analysis of the Structure of Xylans. J. Appl. Spectrosc. 2009, 76, 801–805. [Google Scholar] [CrossRef]
- Bellamy, L.J. The Infrared Spectra of Complex Molecules; Springer: Dordrecht, The Netherlands, 1980; ISBN 978-94-011-6522-8. [Google Scholar]
- Bouilloud, M.; Fray, N.; Bénilan, Y.; Cottin, H.; Gazeau, M.-C.; Jolly, A. Bibliographic Review and New Measurements of the Infrared Band Strengths of Pure Molecules at 25 K: H2O, CO2, CO, CH4, NH3, CH3OH, HCOOH and H2CO. Mon. Not. R. Astron. Soc. 2015, 451, 2145–2160. [Google Scholar] [CrossRef] [Green Version]
- Szymanska-Chargot, M.; Zdunek, A. Use of FT-IR Spectra and PCA to the Bulk Characterization of Cell Wall Residues of Fruits and Vegetables along a Fraction Process. Food Biophys. 2013, 8, 29–42. [Google Scholar] [CrossRef] [Green Version]
- Zhuang, J.; Li, M.; Pu, Y.; Ragauskas, A.; Yoo, C. Observation of Potential Contaminants in Processed Biomass Using Fourier Transform Infrared Spectroscopy. Appl. Sci. 2020, 10, 4345. [Google Scholar] [CrossRef]
- Robert, P.; Marquis, M.; Barron, C.; Guillon, F.; Saulnier, L. FT-IR Investigation of Cell Wall Polysaccharides from Cereal Grains. Arabinoxylan Infrared Assignment. J. Agric. Food Chem. 2005, 53, 7014–7018. [Google Scholar] [CrossRef]
- Deidun, A.; Saliba, S.; Schembri, P.J. Banquette Faunal Assemblages from Groomed and Ungroomed Beaches in the Maltese Islands. Rapp. Comm. Int. Mer Méditerr. 2007, 38, 456. [Google Scholar]
- Deidun, A.; Saliba, S.; Schembri, P.J. Considerations on the Ecological Role of Wrack Accumulations on Sandy Beaches in the Maltese Islands and Recommendations for Their Conservation Management. J. Coast. Res. 2009, 56, 410–414. [Google Scholar]
- Cantasano, N. Management Plan for the Beach-Cast Seagrass in Calabria. In Marine Research at CNR; National Research Council of Italy: Rome, Italy, 2011. [Google Scholar]
- Gómez-Pujol, L.; Orfila, A.; Álvarez-Ellacuría, A.; Terrados, J.; Tintoré, J. Posidonia Oceanica Beach-Cast Litter in Mediterranean Beaches: A Coastal Videomonitoring Study. J. Coast. Res. 2013, 165, 1768–1773. [Google Scholar] [CrossRef] [Green Version]
- Seifert, G.J.; Roberts, K. The Biology of Arabinogalactan Proteins. Annu. Rev. Plant Biol. 2007, 58, 137–161. [Google Scholar] [CrossRef] [PubMed]
- Ellis, M.; Egelund, J.; Schultz, C.J.; Bacic, A. Arabinogalactan-Proteins: Key Regulators at the Cell Surface? Plant Physiol. 2010, 153, 403–419. [Google Scholar] [CrossRef] [Green Version]
- Van Holst, G.-J.; Clarke, A.E. Quantification of Arabinogalactan-Protein in Plant Extracts by Single Radial Gel Diffusion. Anal. Biochem. 1985, 148, 446–450. [Google Scholar] [CrossRef]
- Scheller, H.V.; Ulvskov, P. Hemicelluloses. Annu. Rev. Plant Biol. 2010, 61, 263–289. [Google Scholar] [CrossRef] [PubMed]
- Thomson, J.A. Molecular Biology of Xylan Degradation. Fems Microbiol. Rev. 1993, 10, 65–82. [Google Scholar] [CrossRef]
- Ebringerová, A.; Heinze, T. Xylan and Xylan Derivatives—Biopolymers with Valuable Properties, 1. Naturally Occurring Xylans Structures, Isolation Procedures and Properties. Macromol. Rapid Commun. 2000, 21, 542–556. [Google Scholar] [CrossRef]
- Peña, M.J.; Kulkarni, A.R.; Backe, J.; Boyd, M.; O’neill, M.A.; York, W.S. Structural Diversity of Xylans in the Cell Walls of Monocots. Planta 2016, 244, 589–606. [Google Scholar] [CrossRef] [PubMed]
- Smith, P.J.; Wang, H.-T.; York, W.S.; Peña, M.J.; Urbanowicz, B.R. Designer Biomass for Next-Generation Biorefineries: Leveraging Recent Insights into Xylan Structure and Biosynthesis. Biotechnol. Biofuels 2017, 10, 286. [Google Scholar] [CrossRef]
- Peña, M.J.; Zhong, R.; Zhou, G.-K.; Richardson, E.A.; O’neill, M.A.; Darvill, A.G.; York, W.S.; Ye, Z.-H. Arabidopsis Irregular Xylem8 and Irregular Xylem9: Implications for the Complexity of Glucuronoxylan Biosynthesis. Plant Cell 2007, 19, 549–563. [Google Scholar] [CrossRef] [PubMed] [Green Version]
- Ristolainen, M.; Alén, R.; Malkavaara, P.; Pere, J. Reflectance Ftir Microspectroscopy for Studying Effect of Xylan Removal on Unbleached and Bleached Birch Kraft Pulps. Holzforschung 2002, 56, 513–521. [Google Scholar] [CrossRef]
- Lee, C.; Zhong, R.; Ye, Z.-H. Biochemical Characterization of Xylan Xylosyltransferases Involved in Wood Formation in Poplar. Plant Signal Behav. 2012, 7, 332–337. [Google Scholar] [CrossRef] [PubMed] [Green Version]
- Li, K.; Azadi, P.; Collins, R.; Tolan, J.; Kim, J.S.; Eriksson, K.L. Relationships between Activities of Xylanases and Xylan Structures. Enzym. Microb. Technol. 2000, 27, 89–94. [Google Scholar] [CrossRef]
- Rennie, E.A.; Scheller, H.V. Xylan Biosynthesis. Curr. Opin. Biotechnol. 2014, 26, 100–107. [Google Scholar] [CrossRef] [PubMed]
- Bertaud, F. Evaluation of Acid Methanolysis for Analysis of Wood Hemicelluloses and Pectins. Carbohydr. Polym. 2002, 48, 319–324. [Google Scholar] [CrossRef]
- Harada, N.; Maeda, M. Chemical Structure of Antithrombin-Active Rhamnan Sulfate from Monostrom nitidum. Biosci. Biotechnol. Biochem. 1998, 62, 1647–1652. [Google Scholar] [CrossRef] [PubMed]
- Tako, M.; Tamanaha, M.; Tamashiro, Y.; Uechi, S. Structure of Ulvan Isolated from the Edible Green Seaweed, Ulva pertusa. Adv. Biosci. Biotechnol. ABB 2015, 6, 645–655. [Google Scholar] [CrossRef] [Green Version]
- Tako, M. Structure-Function Relationship of Rhamnan Sulfate Isolated from Commercially Cultured Edible Green Seaweed, Monostroma nitidum. Am. J. Appl. Chem. AJAC 2017, 5, 38. [Google Scholar] [CrossRef] [Green Version]
- Okamoto, T.; Akita, N.; Terasawa, M.; Hayashi, T.; Suzuki, K. Rhamnan Sulfate Extracted from Monostroma Nitidum Attenuates Blood Coagulation and Inflammation of Vascular Endothelial Cells. J. Nat. Med. 2019, 73, 614–619. [Google Scholar] [CrossRef]
- Suzuki, K.; Terasawa, M. Biological Activities of Rhamnan Sulfate Extract from the Green Algae Monostroma Nitidum (Hitoegusa). Mar. Drugs 2020, 18, 228. [Google Scholar] [CrossRef]
- Peralta, A.G.; Venkatachalam, S.; Stone, S.C.; Pattathil, S. Xylan Epitope Profiling: An Enhanced Approach to Study Organ Development-Dependent Changes in Xylan Structure, Biosynthesis, and Deposition in Plant Cell Walls. Biotechnol. Biofuels 2017, 10, 245. [Google Scholar] [CrossRef] [Green Version]
- Busse-Wicher, M.; Li, A.; Silveira, R.L.; Pereira, C.S.; Tryfona, T.; Gomes, T.C.F.; Skaf, M.S.; Dupree, P. Evolution of Xylan Substitution Patterns in Gymnosperms and Angiosperms: Implications for Xylan Interaction with Cellulose. Plant Physiol. 2016, 171, 2418–2431. [Google Scholar] [CrossRef] [PubMed]
- Zarafeta, D.; Galanopoulou, A.P.; Leni, M.E.; Kaili, S.I.; Chegkazi, M.S.; Chrysina, E.D.; Kolisis, F.N.; Hatzinikolaou, D.G.; Skretas, G. Xyndz5: A New Thermostable Gh10 Xylanase. Front. Microbiol. 2020, 11, 545. [Google Scholar] [CrossRef]
- Rencoret, J.; Marques, G.; Serrano, O.; Kaal, J.; Martínez, A.T.; Del Río, J.C.; Gutiérrez, A. Deciphering the Unique Structure and Acylation Pattern of Posidonia oceanica Lignin. ACS Sustain. Chem. Eng. 2020, 8, 12521–12533. [Google Scholar] [CrossRef]
- Tarasov, D.; Leitch, M.; Fatehi, P. Lignin–Carbohydrate Complexes: Properties, Applications, Analyses, and Methods of Extraction: A Review. Biotechnol. Biofuels 2018, 11, 269. [Google Scholar] [CrossRef] [Green Version]
- Wang, H.-M.; Ma, C.-Y.; Li, H.-Y.; Chen, T.-Y.; Wen, J.-L.; Cao, X.-F.; Wang, X.-L.; Yuan, T.-Q.; Sun, R.-C. Structural Variations of Lignin Macromolecules from Early Growth Stages of Poplar Cell Walls. ACS Sustain. Chem. Eng. 2020, 8, 1813–1822. [Google Scholar] [CrossRef]
- Groom, M.J.; Gray, E.M.; Townsend, P.A. Biofuels and Biodiversity: Principles for Creating Better Policies for Biofuel Production. Conserv. Biol. 2008, 22, 602–609. [Google Scholar] [CrossRef]
- Sommer, P.; Georgieva, T.; Ahring, B.K. Potential for Using Thermophilic Anaerobic Bacteria for Bioethanol Production from Hemicellulose. Biochem. Soc. Trans. 2004, 32, 283–289. [Google Scholar] [CrossRef] [PubMed] [Green Version]
- Huber, G.W.; Iborra, S.; Corma, A. Synthesis of Transportation Fuels from Biomass: Chemistry, Catalysts, and Engineering. Chem. Rev. 2006, 106, 4044–4098. [Google Scholar] [CrossRef] [PubMed] [Green Version]
- Jeguirim, M.; Limousy, L. Strategies for Bioenergy Production from Agriculture and Agrifood Processing Residues. Biofuels 2018, 9, 541–543. [Google Scholar] [CrossRef] [Green Version]
- Podkaminer, K.K.; Guss, A.M.; Trajano, H.L.; Hogsett, D.A.; Lynd, L.R. Characterization of Xylan Utilization and Discovery of a New Endoxylanase in Thermoanaerobacterium Saccharolyticum through Targeted Gene Deletions. Appl. Environ. Microbiol. 2012, 78, 8441–8447. [Google Scholar] [CrossRef] [Green Version]
- Dodd, D.; Cann, I.K.O. Enzymatic Deconstruction of Xylan for Biofuel Production. GCB Bioenergy 2009, 1, 2–17. [Google Scholar] [CrossRef] [Green Version]
- Oliveira, D.M.; Mota, T.R.; Salatta, F.V.; Marchiosi, R.; Gomez, L.D.; Mcqueen-Mason, S.J.; Ferrarese-Filho, O.; Dos Santos, W.D. Designing Xylan for Improved Sustainable Biofuel Production. Plant Biotechnol. J. 2019, 17, 2225–2227. [Google Scholar] [CrossRef] [Green Version]
- Masri, M.A.; Younes, S.; Haack, M.; Qoura, F.; Mehlmer, N.; Brück, T. A Seagrass-Based Biorefinery for Generation of Single-Cell Oils for Biofuel and Oleochemical Production. Energy Technol. 2018, 6, 1026–1038. [Google Scholar] [CrossRef] [Green Version]
- Pilavtepe, M.; Celiktas, M.S.; Sargin, S.; Yesil-Celiktas, O. Transformation of Posidonia oceanica Residues to Bioethanol. Ind. Crop. Prod. 2013, 51, 348–354. [Google Scholar] [CrossRef]
- Pfeifer, L.; Classen, B. The Cell Wall of Seagrasses: Fascinating, Peculiar and a Blank Canvas for Future Research. Front. Plant Sci. 2020, 11, 588754. [Google Scholar] [CrossRef]
- Jain, R.K.; Sjöstedt, M.; Glasser, W.G. Thermoplastic Xylan Derivatives with Propylene Oxide. Cellulose 2000, 7, 319–336. [Google Scholar] [CrossRef]
- Stepan, A.M.; King, A.W.T.; Kakko, T.; Toriz, G.; Kilpeläinen, I.; Gatenholm, P. Fast and Highly Efficient Acetylation of Xylans in Ionic Liquid Systems. Cellulose 2013, 20, 2813–2824. [Google Scholar] [CrossRef]
- Tedeschi, G.; Guzman-Puyol, S.; Ceseracciu, L.; Paul, U.C.; Picone, P.; Di Carlo, M.; Athanassiou, A.; Heredia-Guerrero, J.A. Multifunctional Bioplastics Inspired by Wood Composition: Effect of Hydrolyzed Lignin Addition to Xylan–Cellulose Matrices. Biomacromolecules 2020, 21, 910–920. [Google Scholar] [CrossRef]

| Polysaccharide Fraction | Nitrogen Content 1 | Protein Content 1 |
|---|---|---|
| AE | 2.1 | 13.1 |
| AmOx | 1.5 | 9.4 |
| HCl | 0.1 | 0.6 |
| Carb | 0.8 | 5.0 |
| KOH | 0.2 | 1.3 |
| Wavenumber (in cm−1) | AE | AmOx | HCl | Carb. | KOH | Assignment | Literature Reference |
|---|---|---|---|---|---|---|---|
| 3400 | ++ | +++ | +++ | + | + | ν (O-H) | Buslov et al. [50] |
| 3000–2800 | + | ++ | ++ | + | + | ν (CH3), ν (CH2), ν (CH) | Bellamy [51] |
| 2400–2300 | +/− | + | +++ | ++ | +/− | ν (CO2) | Bouilloud et al. [52] |
| 1740 | + | ++ | + | +/− | +/− | ν (C=O) | Szymanska-Chargot & Zdunek [53] |
| 1600 | ++ | ++ | +++ | + | ++ | νasym (COO-) | Buslov et al. [50] |
| 1500 | + | - | - | +/− | ++ | δ (N-H) Amid II; ν (C=C-C) aromatic | Szymanska-Chargot & Zdunek [53]; Zhuang et al. [54] |
| 1420 | + | ++ | ++ | + | + | νsym (COO-) | Buslov et al. [50] |
| 1300 | + | ++ | +++ | + | ++ | ω (CH2) | Zhuang et al. [54] |
| 1250 | + | + | + | +/− | + | ν (C-O) | Szymanska-Chargot & Zdunek [53] |
| 1200–1000 | +++ | +++ | +++ | + | ++ | ν (C-OH) | Buslov et al. [50] |
| 900 | ++ | + | ++ | +/− | +/− | δ (C1-H) | Szymanska-Chargot & Zdunek [53], Robert et al. [55] |
| Monosaccharides | HMF 1 | Yariv Precipitate 1 | Yariv Supernatant 1 |
|---|---|---|---|
| Rhamnose | 5.5 (±1.1) | - | 8.3 (±0.6) |
| Fucose | 4.4 (±0.1) | - | 5.7 (±0.2) |
| Ribose | - | - | 1.6 (±0.2) |
| Arabinose | 11.0 (±2.7) | 18.3 | 11.4 (±0.2) |
| Xylose | 26.4 (±1.8) | 24.5 | 22.6 (±1.7) |
| Apiose | - | - | - |
| Mannose | 8.2 (±0.6) | 7.7 | 8.8 (±0.7) |
| Galactose | 15.5 (±0.9) | 21.8 | 16.5 (±0.6) |
| Glucose | 29.0 (±3.2) | 27.6 | 25.1 (±0.8) |
| Monosaccharides | F1 | F2 |
|---|---|---|
| Rhamnose | - | 1.8 |
| Fucose | - | 0.9 |
| Arabinose | - | 5.3 |
| Xylose | 90.5 | 87.5 |
| Apiose | - | - |
| Mannose | - | - |
| Galactose | - | 3.6 |
| Glucose | 9.5 | 0.9 |
| Uronic acids | n.d. | 12.8 |
| Monosaccharides | Linkage-Type | % (mol/mol) |
|---|---|---|
| Rhamnose (Rhap) | 1- | 8.4 |
| 1,3- | 1.0 | |
| 1,3,4- | 2.4 | |
| Arabinose (Arap) | 1- | 1.0 |
| Xylose (Xylp) | 1- | 4.8 |
| 1,4- | 72.0 | |
| 1,2,4- | 10.4 |
Publisher’s Note: MDPI stays neutral with regard to jurisdictional claims in published maps and institutional affiliations. |
© 2021 by the author. Licensee MDPI, Basel, Switzerland. This article is an open access article distributed under the terms and conditions of the Creative Commons Attribution (CC BY) license (https://creativecommons.org/licenses/by/4.0/).
Share and Cite
Pfeifer, L. “Neptune Balls” Polysaccharides: Disentangling the Wiry Seagrass Detritus. Polymers 2021, 13, 4285. https://doi.org/10.3390/polym13244285
Pfeifer L. “Neptune Balls” Polysaccharides: Disentangling the Wiry Seagrass Detritus. Polymers. 2021; 13(24):4285. https://doi.org/10.3390/polym13244285
Chicago/Turabian StylePfeifer, Lukas. 2021. "“Neptune Balls” Polysaccharides: Disentangling the Wiry Seagrass Detritus" Polymers 13, no. 24: 4285. https://doi.org/10.3390/polym13244285
APA StylePfeifer, L. (2021). “Neptune Balls” Polysaccharides: Disentangling the Wiry Seagrass Detritus. Polymers, 13(24), 4285. https://doi.org/10.3390/polym13244285

